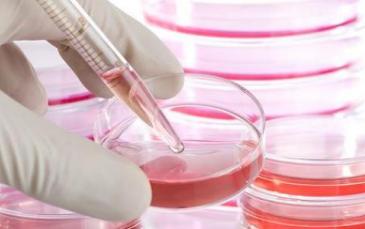

حذر أستاذ طب الأطفال والغدد الصماء والسكري بكلية الطب ومستشفى جامعة الملك عبد العزيز بجدة، البروفيسور عبدالمعين عيد الآغا، حذر مرضى السكري من الاندفاع وراء أي إعلانات وهمية تدعو إلى علاج داء السكري نهائيا عبر زراعة الخلايا الجذعية.
بين الحقيقة والدعاية
تحذير الأغا جاء تزامنا مع تنبيه سفارة المملكة العربية السعودية في أوكرانيا، التي دعت جميع المواطنين إلى توخي الحيطة والحذر بخصوص العلاج عن طريق الخلايا الجذعية.
وقالت السفارة: "يجب عدم الانسياق وراء الإعلانات والحملات الدعائية بجميع أنواعها، والتي يروج لها عن طريق الإنترنت والصحف الإعلانية، وتدّعي إمكانية علاج عدد من الأمراض والحالات الصعبة عن طريق الخلايا الجذعية".
وشدد البروفيسور الأغا، على مرضى السكري وغيرهم، عدم الوقوع كضحايا للإعلانات الترويجية التي تنظمها بعض الجهات الخارجية لاستنزاف جيوب المرضى، منوها إلى أن معظم الحالات، التي تشكو من السكري وقامت بزراعة الخلايا الجذعية، فشلت، وعادت إلى نقطة البداية من خلال العلاج بالأنسولين.
التغلب على التحديات التقنية
وأضاف، الأبحاث المتعلقة بالخلايا الجذعية لعلاج السكري تعطي آمالًا كبيرة، إلا أنه لا يزال هناك الكثير من الجهد الذي يتوجب بذله قبل تحقيقها، فهناك تحديات تقنية لا بد من التغلب عليها أولًا قبل البدء في تطبيق هذه الاكتشافات في العيادات الطبية.
وأردف: مع أن هذه التحديات كبيرة وصعبة إلا أنها ليست مستحيلة، فخبراء البحث الطبي يعتقدون أن الخلايا الجذعية قادرة على تغيير تاريخ الأمراض البشرية عن طريق استخدامها لإصلاح نسيج متخصص أو عن طريق دفعها للنمو بشكل عضو حيوي معين.
وتابع: على الرغم من هذا فإن هذه الأبحاث تثير العديد من المخاوف الأخلاقية والإنسانية، مما اضطر العديد من الدول لوضع تشريعات تحدد هذه الأبحاث.
استغلال حاجة المرضى
وقال: "كما هو معلوم أن مرضى السكري ينتظرون أي بارقة أمل في إنهاء معاناتهم مع داء السكري، وبالتالي فإن هناك من يستغل هذا الجانب ويبدأ في الترويج عن الخلايا الجذعية وغير ذلك، مستغلًا حاجة المرضى عبر وسائل التواصل الاجتماعي.
اشترك في قناتنا على "تيليجرام" ليصلك كل جديد... (https://t.me/Ukr_Press)